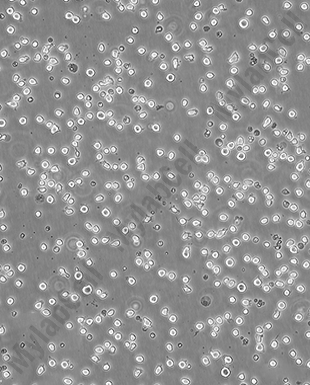

- 细胞类
- 生化试剂
- ELISA检测
-
抗体蛋白
二抗生物素标记 过氧化物酶(HRP)标记 胶体金试剂 FITC荧光标记 RBITC荧光标记 二抗免疫血清 其它荧光标记二抗 藻红蛋白(PE)荧光标记 胶体金(Gold)标记 SAlexa Fluor荧光系列 碱性磷酸酶(AP)标记 别藻蓝蛋白(APC)荧光标记 其它标记 PE标记二抗 DyLight标记二抗 AU标记二抗 Biotin标记二抗 AMCA标记二抗 Texas Red标记二抗 TRITC标记二抗 HRP标记二抗 未标记二抗 Cy标记二抗 AbBox Fluor标记二抗内参抗体 小分子抗体抗体标记试剂盒细菌抗体蛋白病毒包装试剂杂交瘤融合筛选WB、IHC、ELISA相关试剂细胞培养试剂病原微生物抗原抗体假病毒抗体校准品其他抗原抗体标记的标签抗体病理级IHC抗体重组蛋白
- 细胞培养
- 实验耗材
- 仪器设备
- 生化试剂盒
- 小分子试剂
- 基质胶
-
斑马鱼产品
订货时间:周一至周五
订货Q Q:79688691
订货邮件:79688691@qq.com
产品简介-
产品介绍人组织细胞淋巴瘤细胞U-937是NilssonK实验室于1974年从一位罹患组织细胞性淋巴瘤的37岁白人男性的胸腔积液中分离获得的恶性细胞株,具有圆形的单核细胞形态。据报道,U-937细胞能被人混合淋巴细胞培养上清、佛波脂、维生素D3、γ干扰素、肿瘤坏死因子和维甲酸等诱导分化形成终末单核细胞。该细胞表达Fas抗原,且对TNF和抗Fas抗体敏感,不表达免疫球蛋白和EB病毒,受PMA刺激后可产生TNF-α。该细胞系可作为转染宿主,也常被用于毒理学研究。
-
规格T25瓶或者1mL冻存管包装
-
种属人源
-
组织来源胸腔积液;组织细胞淋巴瘤
-
细胞形态单核细胞,圆形
-
生长特性悬浮生长
培养和冻存
运输和保存1.T25瓶复苏的存活细胞常温发货,收到后请按照细胞接收后的处理方法操作。
2.1mL冻存管包装干冰运输,收到后需放入-80度冰箱保存过夜后转入液氮或直接复苏。
收货须知1.收到细胞后,请立即进行检查若发现干冰已挥发干净、冻存管瓶盖脱落、破损及细胞有污染等情况请立即与我司工作人员联系。
2.收到细胞先不开瓶盖,瓶身擦拭酒精后放在培养箱静置2-4小时(视细胞密度而定)稳定细胞状态。接着在倒置显微镜下观察细胞生长情况,并对细胞进行不同倍数拍照(建议收细胞时就整体外观拍一张照片,并观察培养基的颜色以及是否有漏液等情况,随后在显微镜下拍下细胞状态,100*,200*各一张),观察并记录细胞在运输途中是否有污染情况。以上操作可作为我司进行售后服务的依据。
3.由于细胞状态受环境、操作和运输等多方面因素影响,故本司只保证客户收到细胞后一周内的细胞状态,故客户需进行售后服务时需出示收细胞的时间证明及客户提供收货时间和发现问题后与我司工作人员沟通的时间证明,期间间隔时间不能大于7天。
4.所有动物细胞均视为有潜在的生物危害性,必须在二级生物安全台内操作,并请注意防护,所有废液及接触过此细胞的器皿需要灭菌后方能丢弃。
售后说明
注意事项1.本产品仅供科研使用。请勿用于医药、临床诊断或治疗,食品及化妆品等用途。请勿存放于普通住宅区。
2.为了您的安全和健康,请穿好实验服并佩戴一次性手套和口罩操作。
3.实验结果可由多种因素影响,相关处理只限于产品本身,不涉及其他赔偿。
备注:由于产品信息可能会有优化升级,请以实际收货标签信息为准。